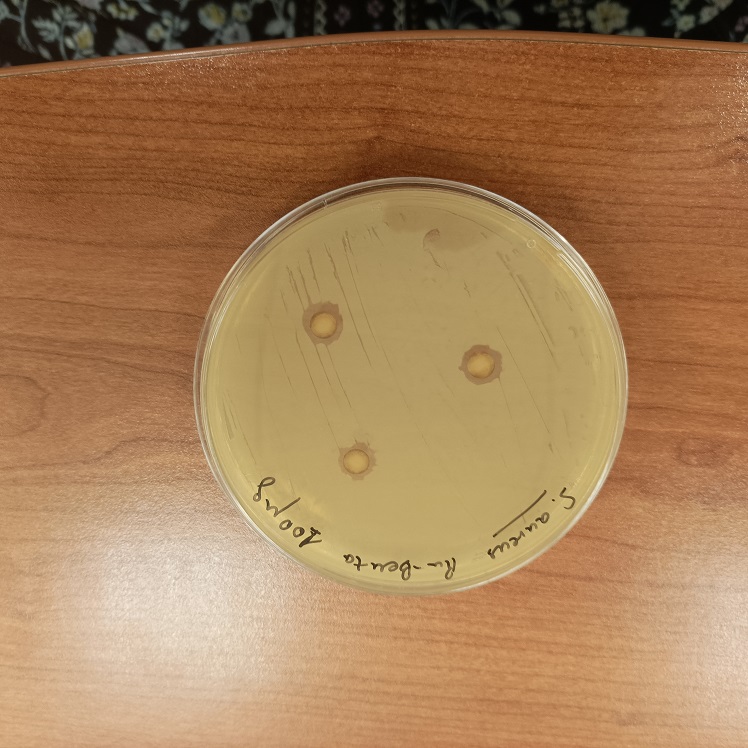

Un ‘caballo de Troya’ diminuto para luchar contra la resistencia bacteriana
Un equipo de investigación de la Universidad de Sevilla ha diseñado una nanocápsula para transportar y dosificar de forma controlada rutenio, un compuesto con capacidad para combatir infecciones por bacterias. La propuesta ofrece una alternativa a los tratamientos convencionales y permite que el fármaco actúe sólo cuando alcanza su objetivo, reduciendo su degradación y posibles efectos no deseados.
Cuando los soldados griegos dejaron a las puertas de Troya un enorme caballo de madera, nadie sospechó que en su interior se escondía la clave de la victoria. La estratagema, basada en introducir al enemigo camuflado para que actuara desde dentro, ha quedado registrada como uno de los episodios más recordados y repetidos de La Eneida (s. I a.C.), obra del poeta romano Virgilio.
En la actualidad, esa misma idea inspira a un equipo de investigación de la Universidad de Sevilla que afronta un desafío muy distinto a la conquista de una ciudad: combatir bacterias cada vez más resistentes a los antibióticos sin dañar el resto del organismo.
Para ello, ha desarrollado un sistema a escala nanométrica capaz de transportar y dosificar de forma controlada rutenio, un metal con capacidad antibacteriana. El objetivo es claro:
- Lograr que el compuesto llegue intacto hasta el microorganismo.
- Que actúe solo donde es necesario.
- Que no se degrade antes de tiempo, una de las grandes limitaciones de este tipo de sustancias.
Cuando los antibióticos dejan de funcionar
El uso continuado de los antibióticos ha provocado que muchas bacterias hayan aprendido a defenderse de ellos. Infecciones que antes se resolvían con facilidad requieren ahora tratamientos más largos, menos eficaces o directamente dejan de tener opciones terapéuticas claras.
Según explican los investigadores, en este contexto, los compuestos basados en rutenio llevan años despertando interés científico por su capacidad para frenar el crecimiento bacteriano. El problema es que, en contacto con el agua, se degradan con rapidez y pierden su efecto, lo que dificulta su aplicación.
La solución propuesta por los expertos consiste en introducir el rutenio dentro de una nanocápsula que lo protege hasta que alcanza su destino. “Si el compuesto se deja libre en disolución, se degrada rápidamente y deja de ser efectivo. Al encapsularlo, conseguimos que se mantenga estable y que solo se active cuando entra en contacto con la bacteria”, explica a la Fundación Descubre Manuel Pernía Leal, investigador de la Universidad de Sevilla.
Una vez dentro del organismo, las nanocápsulas, que poseen un tamaño aproximado de 20 nanómetros -equivalente a una fracción del grosor de un cabello humano, miles de veces más pequeñas que una bacteria- funcionan como un auténtico caballo de Troya. El rutenio permanece inactivo dentro de la nanocápsula hasta que la bacteria la consume. Entonces, se ‘activa’ en su interior y bloquea el crecimiento del microorganismo o lo elimina.
Ensayos de laboratorio
Los experimentos realizados en condiciones de laboratorio y detallados en la revista Small Methods muestran que la propuesta del equipo investigador es eficaz frente a bacterias responsables de infecciones humanas frecuentes, como Staphylococcus aureus o Enterococcus faecalis, especialmente relevantes en infecciones cutáneas, respiratorias y hospitalarias. Además, los ensayos indican que el sistema no muestra efectos tóxicos apreciables en células humanas, un aspecto clave para su posible aplicación en el ámbito sanitario.
Otro de los avances del trabajo es la capacidad de controlar cómo y cuándo se libera el rutenio. Para ello, los investigadores han modificado la superficie de las nanocápsulas con moléculas largas y flexibles que actúan como una especie de malla. “Al introducir estas modificaciones, ralentizamos la salida del compuesto. Así conseguimos una liberación gradual, sostenida en el tiempo y ajustada a las necesidades de cada caso”, señala Pernía Leal.
Por el momento, los experimentos desarrollados por el grupo FQM-102 Estereoquímica y Síntesis Asimétrica se han realizado in vitro, pero el equipo ya trabaja en el diseño de nuevos nanomateriales más potentes y en la mejora de su actividad antimicrobiana. El siguiente paso será avanzar hacia estudios en modelos animales y explorar posibles aplicaciones adicionales en el ámbito de la salud, como el tratamiento dirigido de células cancerosas.
Como aquel caballo de madera que cambió el curso de una guerra, estas diminutas cápsulas podrían convertirse en una herramienta decisiva en la lucha contra infecciones cada vez más difíciles de tratar. La diferencia es que, esta vez, la batalla se libra a una escala invisible al ojo humano.
Más información en #CienciaDirecta: Desarrollan una nanocápsula que dirige fármacos antibacterianos hacia el origen de la infección
Suscríbete a nuestra newsletter
y recibe el mejor contenido de i+Descubre directo a tu email